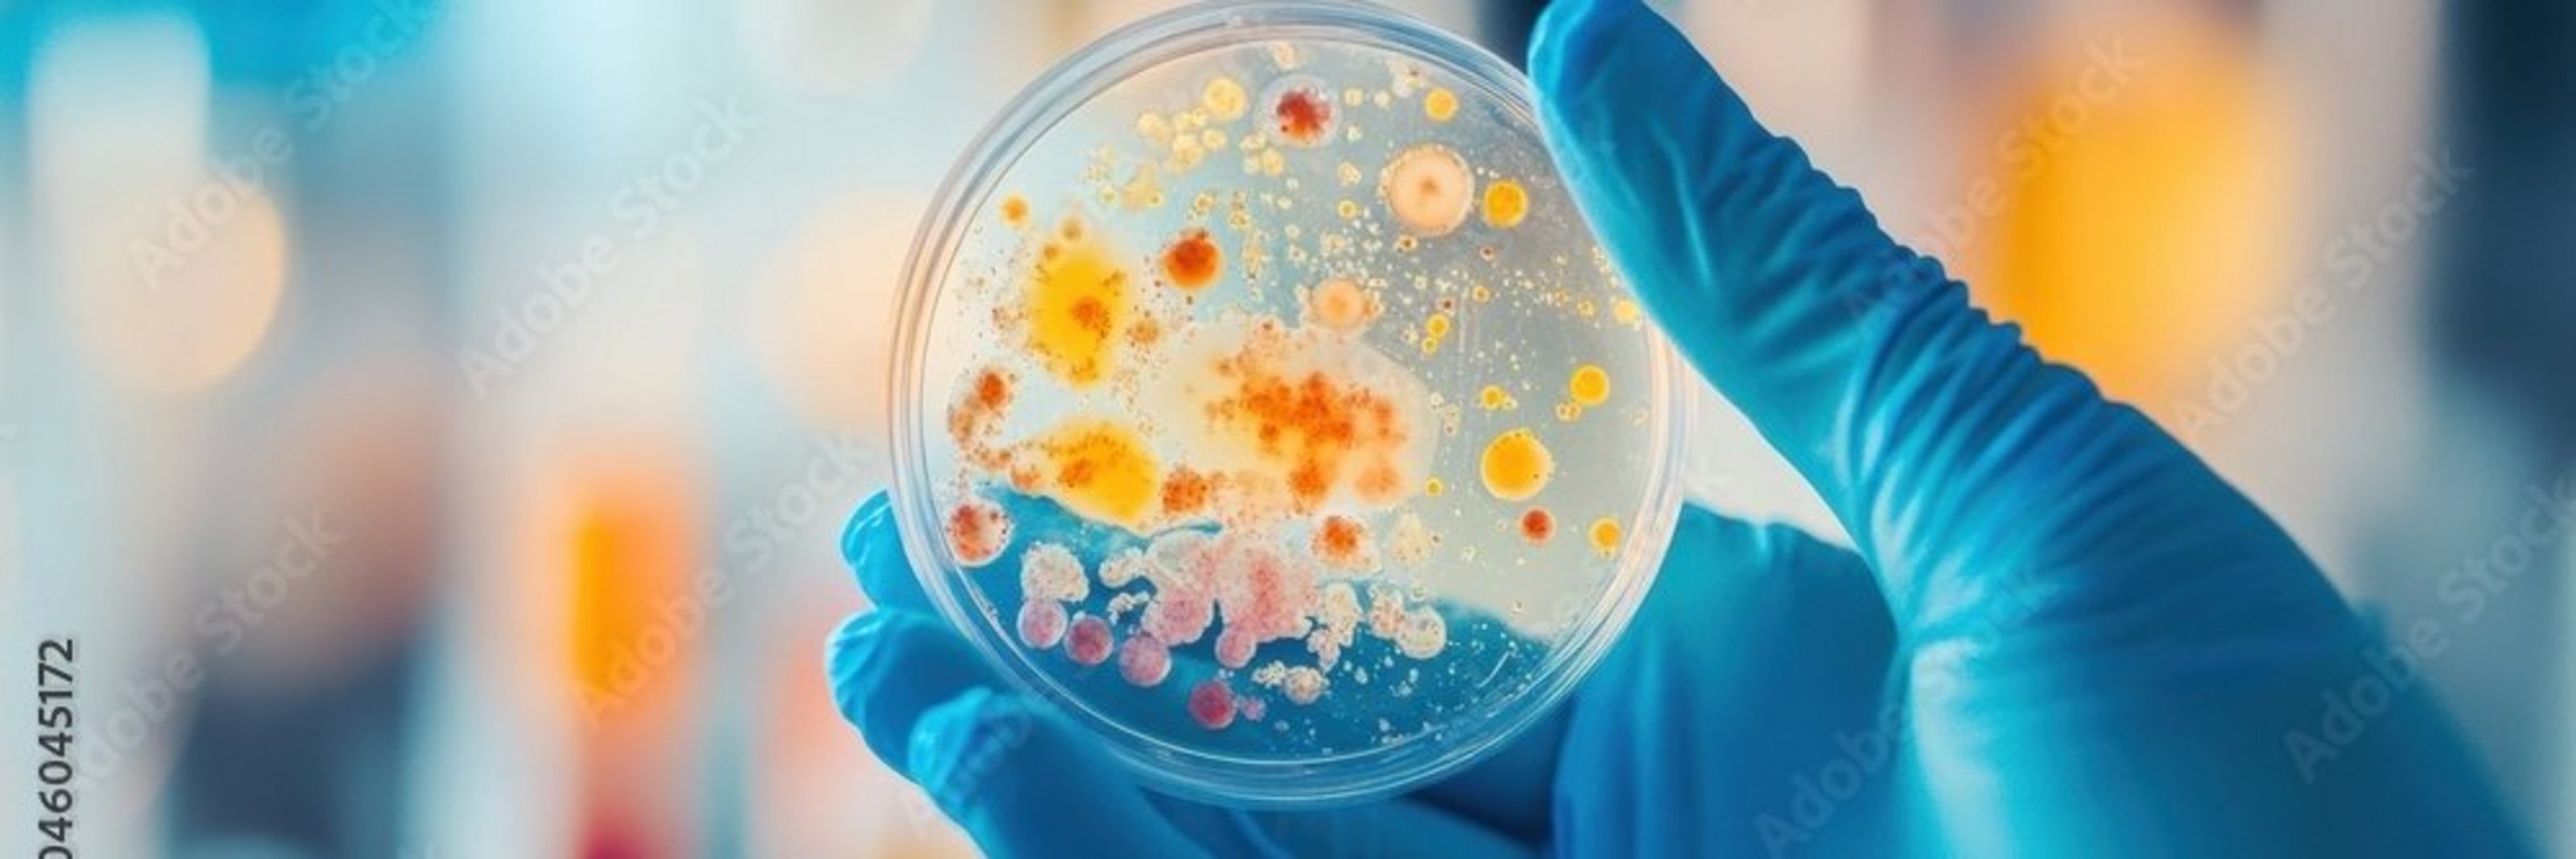

Hilfe
Leichte Sprache
Wir stellen Inhalte unserer Web-Seite in Leichter Sprache zur Verfügung. Das Angebot wird mit Hilfe Künstlicher Intelligenz weiter ausgebaut.
Gebärdensprache
Auf der folgenden Seite stellen wir Informationen in Deutscher Gebärdensprache bereit, die mit Hilfe Künstlicher Intelligenz übersetzt wurden.
Kontakt
Kreis CoesfeldFriedrich-Ebert-Straße 7
48653 Coesfeld 02541 18-0
02541 18-9999 info@kreis-coesfeld.de
Kontaktformular